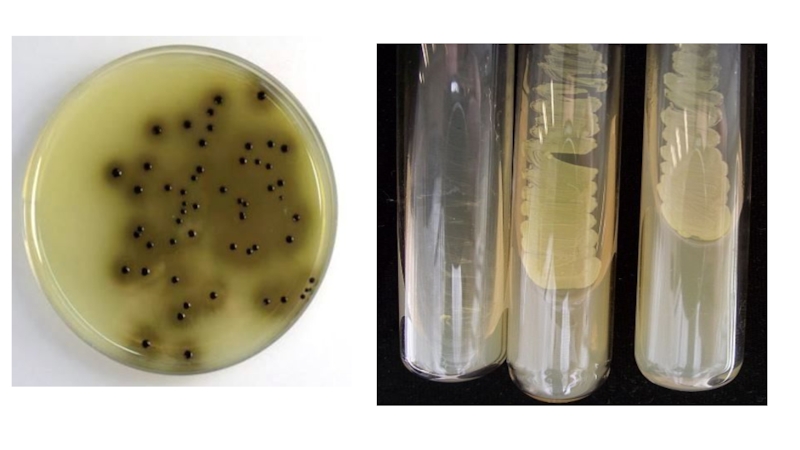
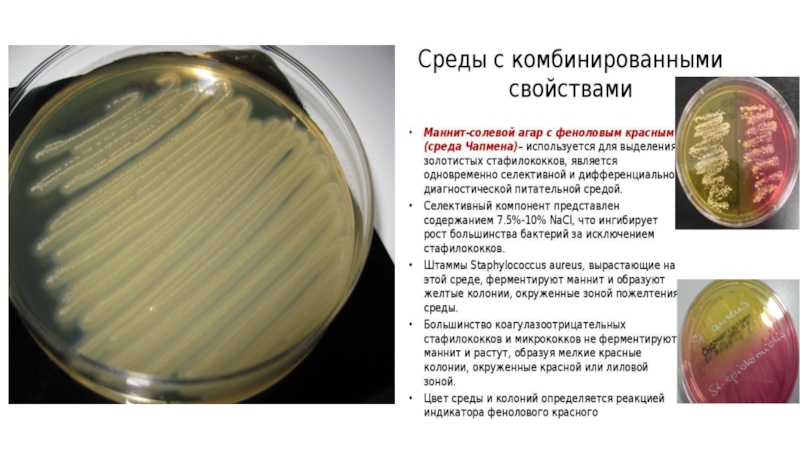

Разделы презентаций
- Разное
- Английский язык
- Астрономия
- Алгебра
- Биология
- География
- Геометрия
- Детские презентации
- Информатика
- История
- Литература
- Математика
- Медицина
- Менеджмент
- Музыка
- МХК
- Немецкий язык
- ОБЖ
- Обществознание
- Окружающий мир
- Педагогика
- Русский язык
- Технология
- Физика
- Философия
- Химия
- Шаблоны, картинки для презентаций
- Экология
- Экономика
- Юриспруденция
Занятие 5
Содержание
- 1. Занятие 5
- 2. Семейство:Enterobacteriaceae Род:Salmonella Вид:S. enteritidis
- 3. Слайд 3
- 4. Биохимические свойства Сальмонеллы ферментируют глюкозу и другие углеводы
- 5. Короткие палочки с закругленными концами, подвижны (перетрихии), спор нет, по Граму окрашиваются отрицательно.
- 6. Культуральные свойстваФакультативные анаэробы, хемоорганотрофы.Способны расти при температуре
- 7. Рост колоний на среде Эндо
- 8. Рост колоний на среде Плоскирева
- 9. Рост колоний на висмут-сульфит агаре
- 10. Рост колоний на селенитовом бульоне
- 11. Рост на магниевой среде
- 12. Слайд 12
- 13. Антигенная структура. Выделяют О-, Н- и К- антигены.
- 14. Факторы патогенности.1.Факторы адгезии и колонизации.2. Способность к
- 15. Факторы вирулентности сальмонеллУстойчивость к действию желудочного сокаФактор
- 16. Источник инфекции – больной человек, бактерионоситель, животные,
- 17. Лабораторная диагностика Бактериологический метод является основным и
- 18. Слайд 18
- 19. Трехсахарный агар с мочевиной
- 20. Слайд 20
- 21. Семейство:Enterobacteriaceae Род:Salmonella Вид:S. typhi
- 22. Источник инфекции: человек, бактерионоситель Механизм передачи: водный,
- 23. Слайд 23
- 24. Слайд 24
- 25. Высев со среды Рапопорт на трехсахарный агар
- 26. Слайд 26
- 27. Слайд 27
- 28. Слайд 28
- 29. Слайд 29
- 30. Слайд 30
- 31. Реакция Видаля. Со второй недели заболевания в
- 32. Поставить реакцию можно двумя способами: капельным и
- 33. Реакция Vi-гемагглютинации. Это наиболее чувствительная реакция для
- 34. Слайд 34
- 35. Возбудители попадают в организм человека с обсемененными
- 36. Постинфекционный иммунитет при брюшном тифе и паратифах
- 37. Специфическая профилактика брюшного тифа Препараты для активной
- 38. Пищевые отравления микробной этиологии пищевые отравления бактериальной
- 39. Слайд 39
- 40. Возбудители пищевых интоксикаций1. Семейство Bacillaceae Род Clostridium
- 41. Слайд 41
- 42. Слайд 42
- 43. Слайд 43
- 44. Слайд 44
- 45. Микробиологическая диагностика ботулизма позволяет обнаружить токсин в
- 46. ИСПОЛЬЗУЕМЫЕ ПИТАТЕЛЬНЫЕ СРЕДЫ
- 47. Слайд 47
- 48. Слайд 48
- 49. Слайд 49
- 50. Слайд 50
- 51. Слайд 51
- 52. Слайд 52
- 53. Скачать презентанцию
Семейство:Enterobacteriaceae Род:Salmonella Вид:S. enteritidis
Слайды и текст этой презентации
Слайд 1Занятие 5
МИКРОБИОЛОГИЧЕСКАЯ ДИАГНОСТИКА БРЮШНОГО ТИФА, ПАРАТИФОВ И ДРУГИХ САЛЬМОНЕЛЛЕЗНЫХ ИНФЕКЦИЙ.
ПИЩЕВЫЕ ОТРАВЛЕНИЯ И ИХ ДИАГНОСТИКА.
Слайд 4Биохимические свойства
Сальмонеллы ферментируют глюкозу и другие углеводы с образованием кислоты
и газа (серотип Salmonella typhi газообразования не вызывает). Обычно не
ферментируют лактозу (на средах с этим углеводом - бесцветные колонии), сахарозу. Оксидаза- отрицательны, каталаза - положительны.Характерные признаки сальмонелл - образование сероводорода, отсутствие продукции индола и аэробность. Для выделения используют дифференциально - диагностические среды (висмут - сульфит агар, среды Эндо, Плоскирева, SS агар) и среды обогащения (селенитовый бульон, желчный бульон, среда Рапопорта). S- формы образуют мелкие (от 1 до 4 мм) прозрачные колонии (на среде Эндо - розоватые, на среде Плоскирева - бесцветные, на висмут - сульфит агаре - черные, с металлическим блеском). На жидких средах S- формы дают равномерное помутнение, R- формы - осадок.
Слайд 5Короткие палочки с закругленными концами, подвижны (перетрихии), спор нет, по
Граму окрашиваются отрицательно.
Слайд 6Культуральные свойства
Факультативные анаэробы, хемоорганотрофы.
Способны расти при температуре от 8 до
450С.
Хорошо размножаются на простых питательных средах. На МПА образуют полупрозрачные,
бесцветные колонии.Среды с желчью являются селективными (желчный бульон, жидкая среда Рапопорт с глюкозой, солями желчных кислот и индикатором Андреде). Способны расти на селенитовом бульоне.
В жидкой среде S-формы вызывают равномерное помутнение.
На дифференциально-диагностических средах Эндо, Левина, МакКонки образуют бесцветные колонии, т.к. сальмонеллы не разлагают лактозу.
Селективной средой для сальмонелл служит висмут-сульфит-агар, где они растут в виде черных блестящих колоний.
Слайд 13Антигенная структура.
Выделяют О-, Н- и К- антигены. К группе К-
антигенов относят Vi- антигены (антигены вирулентности). Благодаря более поверхностному расположению
(чем О- антигены) Vi- антиген может препятствовать агглютинации культур сальмонелл О- специфической сывороткой (экранирование). Для дифференциации сальмонелл применяют схему (серологическую классификацию) Кауфманна - Уайта.В соответствии со структурой О- антигенов сальмонеллы подразделяют на О- группы (67 серогрупп), в каждую из которых входят серологические типы, отличающиеся строением Н- антигенов. Принадлежность сальмонелл к определенному серовару устанавливают при изучении антигенной структуры в соответствии со схемой Кауфманна - Уайта. Примеры: серотип S.paratyphi A относится к серогруппе А, S.paratyphi В - к серогруппе В, S.paratyphi С - к группе С, S.typhi - к серогруппе D.
Слайд 14Факторы патогенности.
1.Факторы адгезии и колонизации.
2. Способность к внутриклеточному паразитированию, препятствовать
фагоцитозу, размножаться в клетках лимфоидной ткани выражены у возбудителей брюшного
тифа, паратифов А и В, способствуя хроническому носительству.3.Эндотоксин (ЛПС).
4. Термолабильные и термостабильные энтеротоксины.
5. Цитотоксины.
6. Существенное значение имеют плазмиды вирулентности и R- плазмиды.
7. Vi - антиген ингибирует действие сывороточных и фагоцитарных бактериоцидных факторов.
Основными факторами патогенности сальмонелл является их способность проникать в макрофаги и размножаться в лимфоидных образованиях собственно слизистого слоя тонкого кишечника, а также продукция эндотоксина.
Слайд 15Факторы вирулентности сальмонелл
Устойчивость к действию желудочного сока
Фактор колонизации: адгезия к
эпителию кишечника
Фактор инвазии: белок наружной мембраны проникает в клетки эпителия
и макрофагиФермент супероксиддисмутаза: устойчивость к фагоцитозу
Эндотоксин: развитие лихорадки
Энтеротоксин: повышение секреции жидкости
Слайд 16Источник инфекции – больной человек, бактерионоситель, животные, птицы Механизм передачи –
алиментарный Путь передачи – пищевой Входные ворота – слизистая тонкого кишечника адгезия, колонизация,
инвазияСлайд 17Лабораторная диагностика
Бактериологический метод является основным и должен применяться в
ранние сроки до начала лечения
Материал для исследования: испражнения, рвотные массы,
промывные воды желудка, кровь, моча, пищевые продуктыПосев материала проводится на среды обогащения и элективные питательные среды
Серологические методы: ИФА, РПГА
Слайд 22Источник инфекции: человек, бактерионоситель Механизм передачи: водный, алиментарный Ведущие звенья патогенеза: циклическое
течение брюшного тифа проявляется пятью периодами изменений в тонкой кишке,
иногда поражается толстая кишка. Первый период: характеризуется набуханием групповых лимфатических фолликулов. Второй период сопровождается некрозом этих образований. Во время третьего периода происходит отторжение некротических масс и формирование язв. Четвертый период – период чистых язв. В пятом периоде происходит заживление язв.Слайд 25Высев со среды Рапопорт на трехсахарный агар и среду Эндо. Высев
на трехсахарный агар проводится для сокращения сроков исследования, так как
мы предполагаем, что на среде Рапопорт уже имеем дело с чистой культурой. Высев на среду Эндо производится для контроля чистоты выделенной культуры. Если на среде Рапопорт росла чистая культура – проводится учет биохимических свойств по трехсахарному агару. Если культура смешанная – проводят откол лактозонегативных колоний со среды Эндо на трехсахарный агар. Учет биохимических свойств по трехсахарному агару. Результат: глюкоза: ферментация до кислоты с выделением газа лактоза и сахароза: нет ферментации сероводород: выделение сероводородаСлайд 31Реакция Видаля. Со второй недели заболевания в крови больных накапливаются
антитела против возбудителя инфекции. Для их выявления исследуют сыворотку крови
больного в реакции агглютинации. В качестве антигена используют убитые культуры сальмонелл - диагностикумы. Для постановки реакции Видаля используют сыворотку больного, набор диагностикумов, изотонический раствор натрия хлорида. Кровь (2-3 мл) из пальца или локтевой вены собирают в стерильную пробирку и доставляют в лабораторию. В лаборатории пробирку ставят в термостат на 20-30 мин для образования сгустка, затем пастеровской пипеткой обводят сгусток, чтобы отделить от стенки пробирки, и ставят на 30-40 мин на холод. Отделившуюся сыворотку отсасывают и используют для постановки реакции агглютинации с диагностикумами из сальмонелл тифа и паратифов. Для получения сыворотки кровь можно отцентрифугировать. При возникновении инфекционного процесса - брюшного тифа или паратифов - в организме вырабатываются О- и Н-антитела к одноименным антигенам возбудителя. О-антитела появляются первыми и исчезают довольно быстро. Н-антитела сохраняются долго. То же самое происходит и при вакцинации, поэтому положительная реакция Видаля с О- и Н-антигенами свидетельствует о наличии заболевания, а реакция только с Н-антигенами может быть и у переболевших (анамнестическая реакция), и у привитых (прививочная). Исходя из этого, реакцию Видаля ставят раздельно с О- и Н-антигенами (диагностикумы). Так как клинически брюшной тиф и паратифы А и В сходны, то для выявления природы заболевания сыворотку больного испытывают одновременно с диагностикумами из сальмонелл тифа и паратифа А и В.Слайд 32Поставить реакцию можно двумя способами: капельным и объемным В практике
чаще используют объемный метод. При постановке линейной реакции агглютинации количество
рядов должно соответствовать количеству антигенов (диагностикумы). Возбудителем заболевания считают микроорганизм, диагностикум из которого агглютинировался сывороткой больного. Иногда отмечают групповую агглютинацию, так как возбудители тифа и паратифов обладают общими групповыми антигенами. В этом случае положительным считают результат реакции в ряду, в котором агглютинацию отмечают в большем разведении сыворотки. В практике реакцию Видаля ставят с четырьмя диагностикумами: брюшного тифа "О" и "Н", а паратифов А и В - с диагностикумами "ОН". Если агглютинация возникает только в небольших разведениях сыворотки - 1:100, 1:200, то для отличия реакции при заболевании от прививочной или анамнестической прибегают к повторной постановке реакции агглютинации через 5-7 дней. У больного титр антител повышается, а у привитого или переболевшего не изменяется. Таким образом, нарастание титра антител в сыворотке крови служит показателем заболевания. В ответ на внедрение в организм возбудителей брюшного тифа, обладающих Vi-антигеном, в крови больного появляются Vi-агглютинины. Их определяют со 2-й недели болезни, но титр их обычно не превышает 1:10. Обнаружение Vi-антител связывают с наличием в организме возбудителей брюшного тифа, поэтому определение этих антител имеет большое эпидемиологическое значение, так как позволяет выявить бактерионосителей.Слайд 33Реакция Vi-гемагглютинации. Это наиболее чувствительная реакция для выявления антител.
Принцип реакции
заключается в том, что эритроциты человека (I группы) или барана
после специальной обработки могут адсорбировать на своей поверхности Vi-антиген и приобретают при этом способность агглютинироваться соответствующими Vi-антителами.Эритроциты с адсорбированными на поверхности антигенами называют эритроцитарными диагностикумами.
Для постановки реакции Vi-гемагглютинации берут:
1) сыворотку крови больного (1-2 мл); 2) эритроцитарный сальмонеллезный Vi-диагностикум; З) Vi-сыворотку; 4) О-сыворотку; 5) изотонический раствор натрия хлорида.
Реакцию ставят в агглютинационных пробирках или в пластмассовых пластинах с лунками.
Кровь у больного берут так же, как для реакции Видаля. Получают сыворотку. Из сыворотки готовят двукратные серийные разведения, начиная с 1:10 до 1:160.
По 0,5 мл каждого разведения вносят в лунку и прибавляют по 0,25 мл эритроцитарного диагностикума. Реакцию ставят в объеме 0,75 мл.
Контролем служат: 1) стандартная агглютинирующая монорецепторная сыворотка + диагностикум - реакция должна быть положительной до титра сыворотки; 2) диагностикум в изотоническом растворе натрия хлорида (контроль) - реакция должна быть отрицательной.
Содержимое лунок тщательно перемешивают, ставят в термостат на 2 ч и оставляют при комнатной температуре до следующего дня (на 18-24 ч).
Учет начинают с контроля. Реакцию оценивают в зависимости от степени агглютинации диагностикума.
Результаты учитывают по четырехкрестной системе:
++++ эритроциты полностью агглютинированы - осадок на дне лунки в виде "зонтика";
+++ "зонтик" меньше, не все эритроциты агглютинировались;
++ "зонтик" маленький, на дне лунки имеется осадок из неагглютинированных эритроцитов;
- реакция отрицательная; эритроциты не агглютинировались и осели на дно лунки в виде пуговки.
Слайд 35Возбудители попадают в организм человека с обсемененными пищевыми продуктами. В
желудке происходит частичная гибель сальмонелл. Воротами инфекции являются клетки слизистой
тонкого кишечника. Здесь сальмонеллы внедряются между ворсинками, колонизируют и повреждают их. Это вызывает умеренное воспаление слизистой оболочки. Эндотоксин, выделяющийся при разрушении сальмонелл, обуславливает интоксикацию. Вырабатываемый сальмонеллами экзотоксин (энтеротоксин) вызывает диарею и рвоту, нарушение водно-солевого обмена и обезвоживание организма. Он обладает также цитотоксическим действием, вызывая гибель энтероцитов. Сальмонеллы проникают в подлежащие ткани слизистой оболочки, транспортируются через нее в макрофаги и могут поступать в лимфу и кровь, вызывая бактериемию и генерализацию инфекционного процесса. Короткий инкубационный период – 12-24 часа. Начала заболевания – острое: озноб, повышение температуры до 390С, интоксикация (головная боль, слабость, тошнота), боли в животе, диспептические расстройства (рвота, понос), признаки обезвоживания организма, падение АД. Заболевание протекает обычно в течение 3-5 дней и заканчивается выздоровлением. При генерализованных формах сальмонеллез протекает более тяжело и длительно. Как субклиническую форму сальмонеллеза рассматривают бактерионосительство (острое – до 3 месяцев, хроническое – более 3 месяцев).Слайд 36Постинфекционный иммунитет при брюшном тифе и паратифах – гуморальный, напряженный,
длительный (не менее 15-20 лет, часто пожизненный). Образуются антитела к
О-, Н-, Vi-антигенам: Первыми к концу 1-й недели заболевания появляются антитела к О-АГ, достигая максимума к периоду разгара (14-15 дней), а затем исчезают. Антитела к Н-АГ появляются к концу 2-й недели, достигая максимума в период реконвалесценции и длительно сохраняясь в организме после перенесенного заболевания. Антитела к Vi-АГ обнаруживаются у бактерионосителей брюшного тифа. Постинфекционный иммунитет при сальмонеллезах – гуморальный и клеточный, типоспецифический, ненапряженный и недлительный, опосредован SIgA.Слайд 37Специфическая профилактика брюшного тифа Препараты для активной иммунизации против брюшного тифа –
Вакцина брюшнотифозная спиртовая сухая Для профилактики БТ у взрослых (мужчины до
60 лет, женщины до 55 лет). Вакцинацию проводят двукратно с интервалом 25-35 суток в дозе: 1-я вакцинация – 0,5 мл, 2-я вакцинация – 1,0 мл. Ревакцинацию проводят через 2 года в дозе 1,0 мл. Препарат вводят п/к в подлопаточную область. – Вакцина брюшнотифозная спиртовая, обогащенная Ви-антигеном Для профилактики БТ у детей от 7 до 14 лет. При однократной аппликации обеспечивает защиту от заболевания в течение 2 лет. Вакцинацию проводят п/к однократно в дозе 0,5 мл. Ревакцинацию проводят в той же дозе через 2 года. – Вакцина брюшнотифозная Ви-полисахаридная жидкая (Вианвак) Препарат для профилактики БТ у взрослых. Прививку проводят п/к однократно в дозе 0,5 мл (25 мкг). Ревакцинации проводятся каждые 2 года. – Тифим Ви (Typhim Vi) Высокоочищенная антигенная фракция Vi-антигена, не содержит цельных бактерий. Рекомендована ВОЗ для профилактики БТ у детей с 2 лет и взрослых. После п/к введения одной дозы вакцины (0,5 мл) протективные титры антител (4-х кратное нарастание) отмечаются через 15-21 день, сохраняясь в течение 3 лет. Фагопрофилактика – Бактериофаг брюшнотифозный в таблетках с кислотоустойчивым покрытием Препарат предназначен для профилактики БТ. Применяют орально за 1-1,5 часа до приема пищи по 2 таблетки (по 0,2 г каждая) 1 раз в 3 дня или ежедневно до ликвидации вспышки, в зависимости от эпидемической обстановки и степени распространенности инфекции. Реакции на введение препарата и противопоказания к его применению отсутствуют.Слайд 38Пищевые отравления микробной этиологии
пищевые отравления бактериальной природы:
Пищевые токсикоинфекции (ПТИ):
- вызванные
некоторыми видами сальмонелл;
- вызванные условно-патогенными кишечными бактериями (E.coli, Proteus, Enterococcus
и др.);- вызванные некоторыми спорообразующими бактериями (Clostridium perfringens, Bacillus cereus);
- вызванные некоторыми стрептококками – гемолитическим и зеленящим;
Пищевые интоксикации (токсикозы):
- ботулизм;
- стафилококковая интоксикация.
Пищевые отравления грибковой природы – микотоксикозы:
Слайд 40Возбудители пищевых интоксикаций
1. Семейство Bacillaceae Род Clostridium
Вид
Cl.botulinum
2. Семейство Bacillaceae Род Clostridium
Вид Cl.perfringens
3. Семейство
Micrococcaceae Род StaphylococcusВид S. aureus